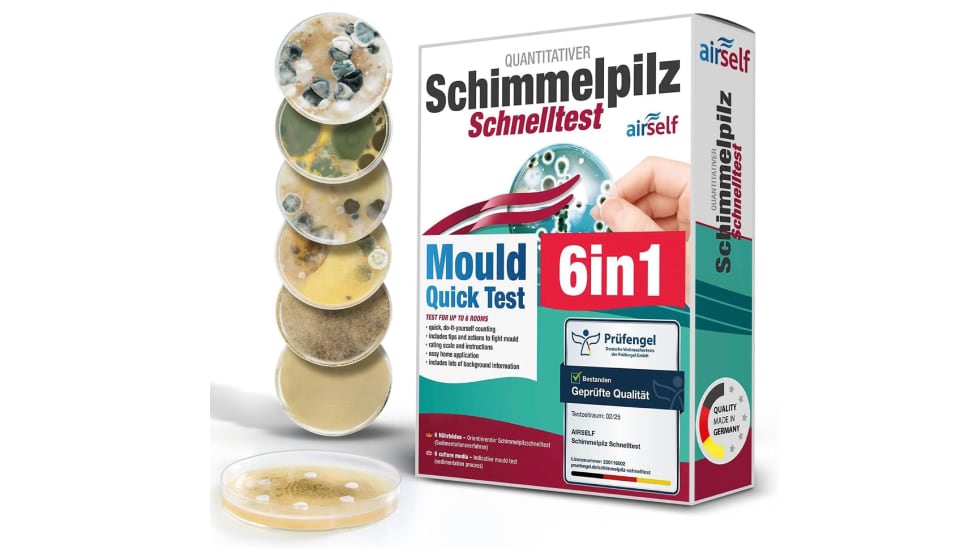
Test de moho en casa barato (incluye seis unidades).

Este test de moho para casa ofrece resultados rápidos y precisos: así funciona
![Identificación fotográfica] Identificación fotográfica]](https://wanted.love/uploads/news-logo/2026/02/15/11614/big-62e3d44475.png?auth=b108f72f78613a20dc1a8f4a3c7aec04b97ab1bcdcb933c0d4fe1bbcd7be2ea3) 15 Febrero 2026, 08:15
15 Febrero 2026, 08:15 
Como ya sabemos, el moho en casa es un inconveniente que hay que tomárselo en serio porque siempre surge por uno o varios motivos concretos. Identificar restos de moho en casa, sobre todo, los más visibles es la primera señal para actuar en consecuencia y decirle adiós al problema una vez retirado. Sin embargo, la aparición de estas bacterias no siempre se ve a simple vista. A veces, las indagaciones se hacen mediante el olfato o por causas indirectas en paredes y techos. Sea como fuere, y si nos preocupa este ámbito del hogar, siempre podemos adquirir un test de moho doméstico de resultados rápidos y precisos por nosotros mismos. Dicha prueba se vende a un precio muy asequible en Amazon.

Fuente:
EL PAÍS: el periódico global
Comentarios (0)
